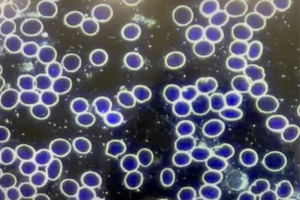

Chronic Pathogen Colonization of the Spike Protein
Now they Call it VAIDS – Vaccine Acquired Immune Deficiency Syndrome
Everyone Who was Vaxxed & Has Had the Virus Is Suffering Long-Term Spike Protein Damage – only those that had a quick immune response were saved the replicating nature of the spike protein which acts more like a parasite
Long Haul Corona Virus Infection is actually a blood disorder causing Progressive Heart and Neurodegenerative Disease – inroads to early heart attacks, embolisms, Parkinsons’ and other brain conditions caused by thickening of blood starving the brain and accelerating oxidative stress – There is even an official medical term for the condition – Chronic Pathogen Colonization
Full Article from Medical Workshop on “Long Haul Corona Virus”
Does anyone out there really think that a cold type virus lingers for months? Why do people minimize this very serious condition to a long-standing virus?
I just completed a workshop at the American Academy of Ozonotherapy where a number of doctors and scientists shared their experiences and their positive patient outcome solutions.
Here is what is really going on…
numbers in paragraphs are references from PubMed
Chronic Pathogen Colonization (CPC)
CPC generates toxins and pro-oxidant pathogen metabolic byproducts “24/7” (including a large amount of free iron), and these are continually swallowed, making the creation and maintenance of a normal gut flora (microbiome) nearly impossible as long as the CPC persists. This inability to fix the gut once and for all (which requires stopping what has caused the damage – we teach you this) makes it nearly impossible to clear CPC.
Is a “Leaky Gut” Really a Chronic Disease?
The intestinal epithelial cells have one of the highest turnover rates anywhere in the body, with intestinal stem cells working to have each epithelial cell replicated anew between every 3 to 5 days [32567155]. This also means that when an “old” cell is once again replicated, the contribution of that cell to a leaky gut ceases, as it begins its existence providing a renewed normal barrier function with other regenerated cells.
This begs the question: Is leaky gut syndrome really a chronic disease, or the chronic presence of ongoing acute toxin exposures? It would appear to be the latter.
Regarding oxidative damage anywhere in the body, Dr. Huggins said “You can’t dry off while you are still in the shower.” And it’s true!
The evidence is continuing to emerge that when you stop poisoning the newly generated cells with swallowed products of CPC, even a long-standing leaky gut can completely heal, and often quite quickly.
Progression of Chronic Pathogen Colonization (CPC)
Once present, CPC generally persists indefinitely, due to tenacious biofilms, and this “pathogen residue” of a cold or a bout of influenza can persist, literally for life, until specific measures are taken to eradicate it.
The presence of a significant degree of CPC is an important additional factor in determining the clinical responsiveness of a patient with a newly acquired COVID infection. Effectively eliminating CPC is a major factor in determining how quickly and completely someone can recover from COVID-19 or any other respiratory virus, as well as how effectively initial infection can be avoided.
Eradicating areas of CPC requires an agent that destroys biofilms and then subsequently destroys, or allows something else to destroy, all variety of pathogens.
COVID and the Spike Protein
Although they are found on many different cells throughout the body, the ACE2 receptors on the epithelial cells lining the airways are the first targets of the virus upon exposure by inhalation [32142651]. Of note, the concentration of these receptors is especially high on lung alveolar epithelial cells, causing a disproportionate degree of viral attraction to the lung tissue [32305506]. When enough virus has been bound by these ACE2 sites and virus replication ensues inside those cells, the unchecked process eventually leads to the adult respiratory distress syndrome (ARDS), low blood oxygen levels, and the burst of oxidation known as the cytokine storm, leading shortly to death thereafter [32364961, 33195436, 32592501].
As ACE2 receptors are present in many tissues throughout the body, “free” circulating spike protein can become bound just about anywhere. Increased thrombosis (abnormal blood clotting) has been seen following vaccination and it has been asserted that the spike protein-binding of ACE2 receptors on both platelets and the lining of the blood vessels (endothelium) are responsible for the increased thrombosis [32887634, 33223324, 34356644]. There is also evidence indicating that “long-haul COVID” is either a persistent low-grade viral infection and/or a persistent presence of the spike protein. As the vaccine is asserted to be an injection of spike proteins, it would appear that anti-spike protein measures might effectively treat both vaccine-related symptoms as well as long-haul COVID symptoms.
While some people react poorly to COVID vaccination, many appear to do well and feel completely fine after their vaccinations. Is this an assurance that no harm was done by the vaccine? Some striking anecdotal evidence suggests otherwise, while also indicating options for optimal protection against side effects in both the short- and long-term.
Red Blood Cell Facts
The smallest capillaries through which a red blood cell (RBC) must pass to continuing circulating are actually slightly smaller in diameter than the diameter of the normal RBC. As such, it has been conclusively shown that in the microcirculation the RBCs have to bend or fold slightly in order to make the transition from the arterial to the venous side of the circulation.
COVID and Thrombosis
An elevated D-dimer test indicates an increased presence of the breakdown products of blood clots. D-dimer levels have been found to be consistently elevated in both COVID infections as well as in some vaccinated individuals with thrombotic complications. Not surprisingly, patients with higher D-dimer levels for longer periods of time are the sickest and show the greatest mortality [34259661, 32997543, 32853982, 32903841].
It also appears that the spike protein itself is intrinsically toxic, and the measures that neutralize the impact of any toxin (like properly-dosed vitamin C) can be effectively utilized against spike protein. D-dimer levels must drop to levels below 0.5 microgram/cc (500 ng/cc) before treatments for abnormal blood clotting are discontinued, regardless of absence of any symptoms, unless a underlying medical condition unrelated to spike protein is felt to be provoking the increase in D-dimer levels. D-dimer levels can be elevated in advanced age, pregnancy, trauma, post-operative periods, inflammatory states, and cancer. Except for age, such conditions are not necessarily permanent, meaning long-term D-dimer should still return to normal [35176874]
Red Blood Cell Rouleaux Formation
Under conditions of inflammation and increased oxidative stress, RBCs can aggregate face-to-face to form coin-like stacks, with even branching of the stacks when very pronounced. This is known as rouleaux formation [6426540]. Not surprisingly, when rouleaux formation is pronounced, blood viscosity (thickness) results, and there is increased resistance to the normal, easy flow of the blood, especially in the microcirculation [2731173]. This rouleaux formation also impairs the ability of the blood to optimally transport oxygen to the tissues (another feature of COVID spike protein impact) [10711739]. Rouleaux formation is easily visually directly with dark field microscopy. It is likely, although yet to be conclusively proved, that rouleaux formation can positively correlate to the propensity of the blood to clot, and to elevated D-dimer.
Evidence of Post-Vaccination Rouleaux and Resolution
The following two slides are dark field blood examinations. The first one was taken from a 62-year-old female who had received the COVID vaccine roughly 60 days prior to the examination of the blood. Note that there is mild RBC clustering formation, consistent with minimal rouleaux formation. The slide after that shows a dark field blood exam on the same patient after six autohemotherapy ozonations (“passes”). There is complete resolution of the rouleaux formation of the blood.
62-year-old female, 60 days post-COVID vaccination, Dark Field Blood Examination

Same 62-year-old female, Dark Field Blood Examination Directly After 6 Pass Blood Ozone Treatment
Evidence of Post-Vaccination Rouleaux and Resolution
A second patient, a young adult male who received his vaccination 15 days earlier and feeling fine, without any noteworthy symptoms developing post-vaccination. The first dark field blood examination displays severe rouleaux formations of the RBC, appearing to literally involve all of the RBC fields visualized in an extensive review of the blood sample. After only an ozonated saline infusion followed by a 15,000 mg infusion of vitamin C, the rouleaux completely resolved. The subsequent slide showed that this return to normalcy was still present another 15 days after the two infusions, giving good reassurance that the treatments had some durability, if not permanency.
Dark Field Blood Examination 15 days post-COVID vaccination

Dark Field Exam Directly after Ozonated Saline and IV Vitamin C Infusions

Thrombolytic Therapy
Many COVID and post-COVID protocols advocate some form of anticoagulation interventions, but no recommendations for thrombolysis, except when blood clots are large, widespread, and life-threatening. Much evidence exists to indicate that long-term supplemental thrombolytics decreases the symptoms in many different conditions, including COVID [34248612, 34124160, 28264497, 29531018, 24416067, 29983558, 15584386, 28648640]. But even if not used for general health reasons, a course of such supplementation should be given for chronic COVID and post-vaccine symptoms along with anti-spike protein therapies to restore the circulation to as completely a normal state as possible.
Medical Director, The Biosanctuary



